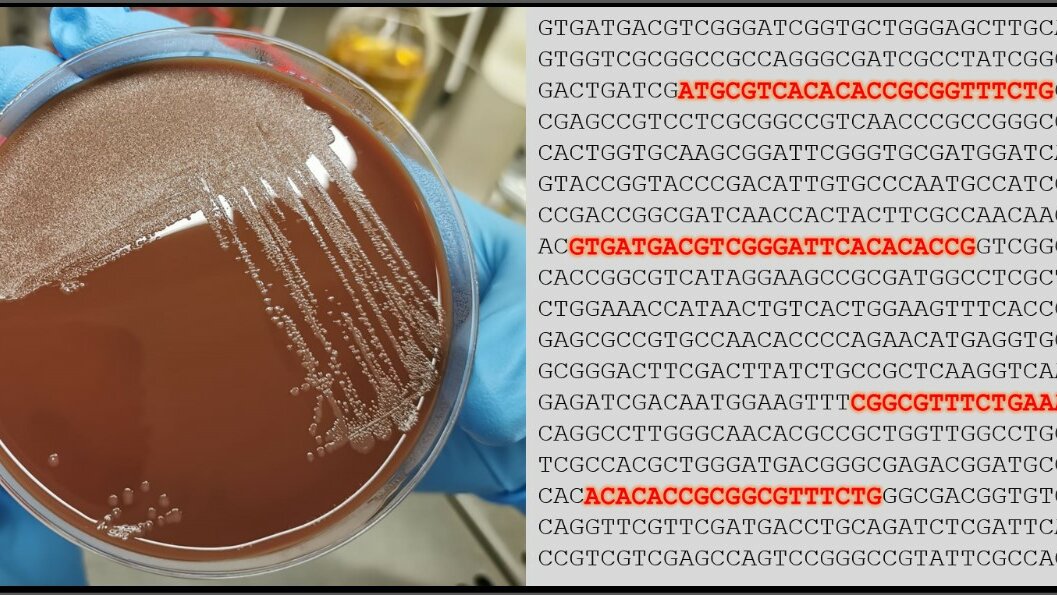
Foto_Haemophilus_Kultur_Ergbutanalyse_FZBtif.jpg

Diese Bakterien besiedeln oft Nase, Mund und Rachen, sind in der Regel aber harmlos. Bei Neugeborenen, Kleinkindern oder älteren Menschen mit geschwächtem Immunsystem, können Sie jedoch schwere Erkrankungen, wie z.B. eine Lungenentzündung oder Sepsis, verursachen. Die Wissenschaftler*innen des Forschungszentrums Borstel, Leibniz Lungenzentrum und des UKSH am Campus Lübeck haben nun eine Methode entwickelt die Spezies der Bakterien genau zu bestimmen und Stamm-spezifische Antibiotikaresistenzen aus dem Erbgut der Bakterien herauszulesen.
Gezielte Antiobiotikabehandlung
Ziel ist es, in Zukunft allein durch die Analyse des Bakteriengenoms in einer Patientenprobe zeitnahe und valide Empfehlungen für eine gezielte Antibiotikabehandlung zu liefern und so die Präzisionsmedizin am UKSH zu stärken. Vor der weitverbreitenden Einführung einer Impfung gegen Haemophilus influenzae mit dem Kapseltyp b (Hib) in den 2000er Jahren sind nach Schätzungen der Weltgesundheitsorganisation (WHO) jährlich etwa 8 Millionen Kinder an diesem Bakterium erkrankt und bis zu 400.000 Kinder an den Folgen der Erkrankung gestorben. Die Impfung konnte die Ausbreitung dieses speziellen Haemophilus Stamms (Hib) erfolgreich stoppen, jedoch sind gerade Häufigkeit und Schwere der Infektionen mit anderen Haemophilus-Spezies bislang wenig untersucht. „Wir glauben, dass gerade diese bislang wenig untersuchten Haemophilus-Isolate durchaus schwere Infektionen verursachen können und sehen mit Sorge, dass auch zunehmend resistente Erreger isoliert werden“, Prof. Jan Rupp, Direktor der Klinik für Infektiologie und Mikrobiologie am UKSH Lübeck.
Neue Methode entwickelt
In Zusammenarbeit mit Dr. Margo Diricks, Prof. Stefan Niemann und Prof. Matthias Merker am Forschungszentrum Borstel, Leibniz Lungenzentrum hat das Forscherteam das Erbgut von über 1.500 Bakterien der Gattung Haemophilus untersucht. Dabei haben die Wissenschaftler*innen eine Methode entwickelt, die es ermöglicht schnell aus den Rohdaten einer bakteriellen Erbgutanalyse (Genomsequenzierung) wichtige Marker zur Vorhersage von Antibiotikaresistenzen zu detektieren sowie den genauen Typ des Bakterienstammes zu bestimmen. „Wir haben beispielsweise neue Hinweise gefunden, dass auch Bakterien der vermeintlich harmlosen Spezies Haemophilus haemolyticus möglicherweise zu schweren Erkrankungen führen können“, erläutert die Erstautorin der Studie Dr. Margo Diricks.
Bakterien-Profil mit allen Resistenzgenen
„Unser Ziel ist es nun diese Methode weiter zu entwickeln, um in Zukunft direkt aus einer Patientenprobe ein genaues Bakterien-Profil mit allen Resistenzgenen (dem „Resistom“) und möglichen Virulenzfaktoren zu erstellen“, sagt Prof. Merker, Leiter der Nachwuchsgruppe „Evolution des Resistoms“ am Forschungszentrum Borstel, Leibniz Lungenzentrum. Die Ergebnisse der Arbeit wurden in der renommierten Fachzeitschrift „Genome Medicine“ veröffentlicht und durch den Exzellenzcluster PMI unterstützt.
Quelle: Forschungszentrum Borstel
Artikel teilen